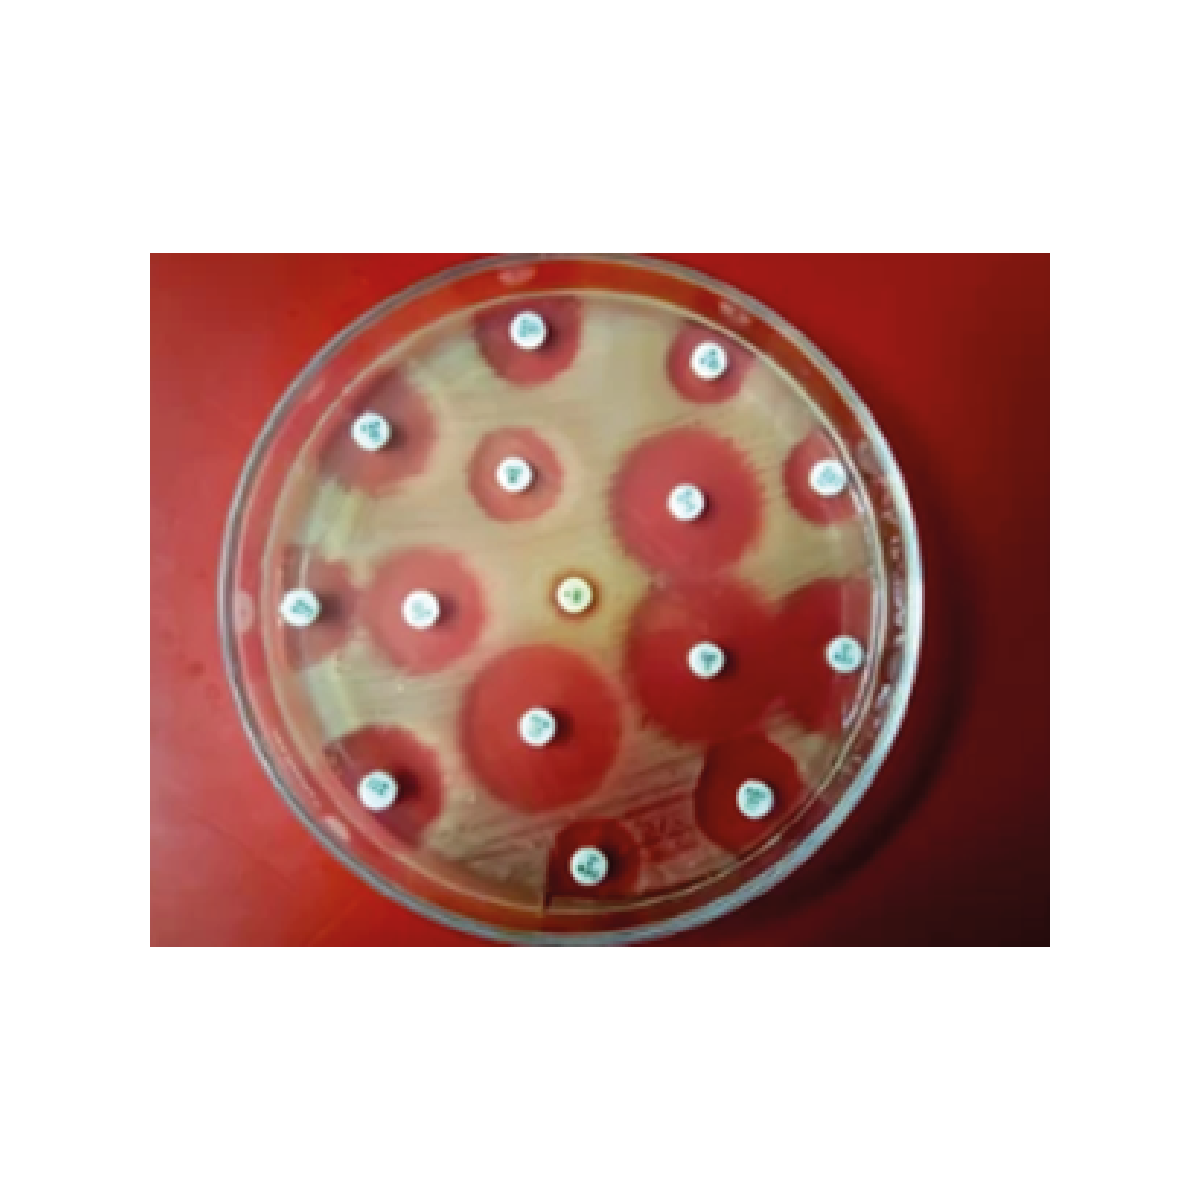

Oxoid UK Tilmicosin TIL Discs 15ug 5×50 / Oxoid UK Discos Tilmicosin TIL de 15 ug de 5 x 50
Evalúe la sensibilidad de los microorganismos utilizando métodos AST manuales, con la ayuda de una amplia selección de discos para antibiogramas. Estos discos, de alta calidad y fáciles de usar, permiten realizar pruebas precisas y eficientes, garantizando resultados confiables para determinar la eficacia de diversos antibióticos.